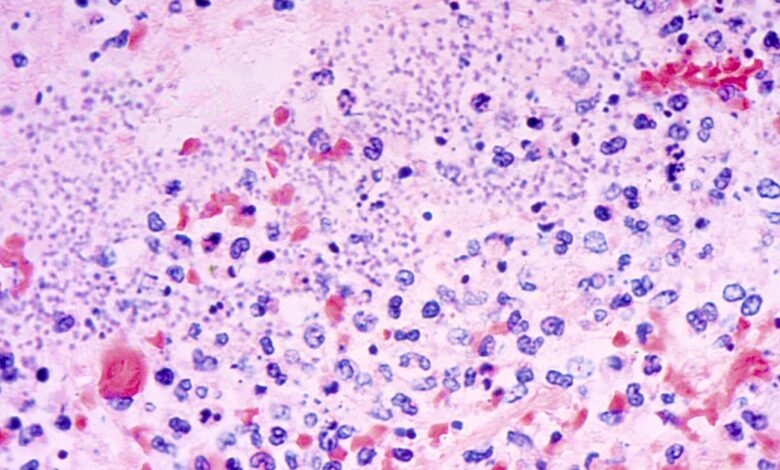

Plague kills Arizona resident, marking first recorded death since 2007, health officials say
A tragic incident has occurred in northern Arizona, where a resident has passed away from pneumonic plague, as confirmed by health officials on Friday.
Pneumonic plague is a rare bacterial infection that affects humans, with an average of seven cases reported annually in the United States, mostly concentrated in the western states, according to federal health authorities.
The recent death in Coconino County, which encompasses Flagstaff, marks the first recorded fatality from pneumonic plague since 2007, as stated by local officials. Details regarding the individual’s identity have not been disclosed.
Expressing condolences, Coconino County Board of Supervisors Chair Patrice Horstman emphasized, “Our hearts go out to the family and friends of the deceased during this difficult time. Out of respect for the family, no further information will be provided regarding the death.”
Plague, also known as “The Black Death,” was responsible for the devastating loss of life in 14th century Europe, claiming the lives of millions. It swept through Europe, the Middle East, and Africa from 1346 to 1353, decimating up to 60% of the population in those regions.
Fortunately, modern medicine has made treating plague with antibiotics highly effective.
The bubonic plague, transmitted through infected rodents like prairie dogs and rats, is the most common form of this bacterial infection. The other two variants include septicemic plague, affecting the entire body, and pneumonic plague, targeting the lungs.
Pneumonic plague is deemed the most lethal and easily transmissible form of the disease.
The transmission of the bacteria occurs through fleas’ bites, which can pass the infection between rodents, pets, and humans. Additionally, contact with infected bodily fluids can also lead to contracting the plague. Health experts advise caution when handling sick or deceased animals to prevent infection.
The majority of plague cases occur in rural regions of northern New Mexico, northern Arizona, southern Colorado, California, southern Oregon, and far western Nevada, as reported by the Centers for Disease Control and Prevention. Between 1970 and 2020, a total of 496 plague cases were documented, with over half of them reported in New Mexico.
In a concerning development, a human case of plague emerged in Southern Colorado last July following the death of a New Mexico resident from the same disease in March.





